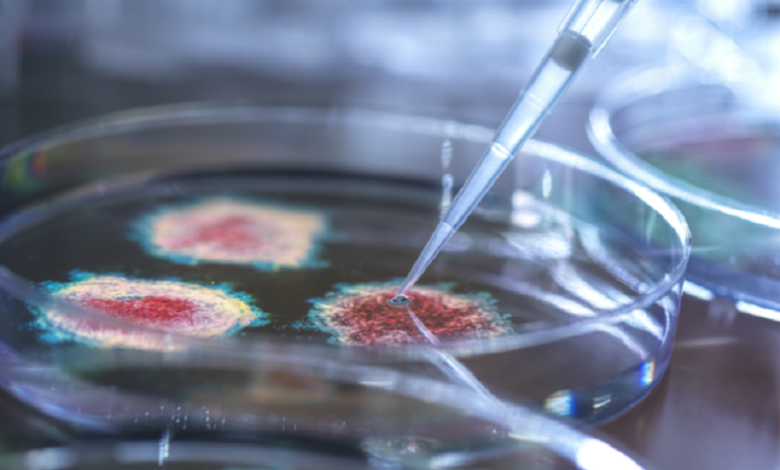
علماء يكشفون عن لقاح ثوري يحمي من نزلات البرد والإنفلونزا و«كوفيد-19» في جرعة واحدة 3

شمسان بوست / المصدر: RT أعلنت الهيئة القومية لسلامة الغذاء في مصر إصدارها قرارا بسحب واسترجاع عدد من منتجات ألبان…
أكمل القراءة »صحة
شمسان بوست / متابعات: أظهرت دراسة علمية حديثة أن شاي الرويبوس المخمّر، المعروف على نطاق واسع كمشروب خال من الكافيين،…
أكمل القراءة »شمسان بوست / متابعات: طور علماء من جامعة ستانفورد لقاحا واعدا يمكن أن يوفر حماية شاملة ضد نزلات البرد والإنفلونزا…
أكمل القراءة »شمسان بوست / متابعات: أظهرت دراسة أجراها علماء من جامعة روفيرا إي فيرجيلي الإسبانية أن زيت الزيتون البكر الممتاز يعزز…
أكمل القراءة »شمسان بوست / متابعات: بينما يحذر الأطباء مرضى السكري من العصائر المحلاة في رمضان، فإنهم يبدون في الوقت نفسه تسامحا…
أكمل القراءة »شمسان بوست / متابعات: قبل أيام قليلة من بداية شهر رمضان، ظهرت بالتزامن نتائج دراسة استمرت نحو 70 عامًا، لتكشف…
أكمل القراءة »شمسان بوست / متابعات: يرتبط توقيت تناول الحلوى بتأثير مباشر على مستويات السكر في الدم، إذ تشير أبحاث إلى أن…
أكمل القراءة »شمسان بوست / متابعات: الزيوت من المكونات الأساسية في أي مطبخ، من زيت الزيتون إلى زيوت الطهي عالية الحرارة، إلا…
أكمل القراءة »شمسان بوست / متابعات: يبدأ خطر إصابة الرجال بالنوبات القلبية بالارتفاع منذ منتصف الثلاثينات من العمر، أي قبل النساء بنحو…
أكمل القراءة »شمسان بوست / متابعات: أظهرت دراسة حديثة أن الأشخاص الذين اتبعوا نظاماً غذائياً منخفض السعرات الحرارية، يتكوّن أساساً من الشوفان،…
أكمل القراءة »